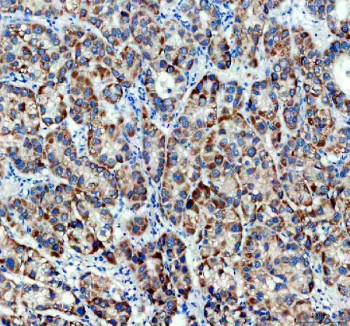
Anti-TIMM50 / Translocase of inner mitochondrial membrane 50

Cookie preferences
This website uses cookies, which are necessary for the technical operation of the website and are always set. Other cookies, which increase the comfort when using this website, are used for direct advertising or to facilitate interaction with other websites and social networks, are only set with your consent.
Configuration
Technically required
These cookies are necessary for the basic functions of the shop.
"Allow all cookies" cookie
"Decline all cookies" cookie
CSRF token
Cookie preferences
Currency change
Customer-specific caching
FACT-Finder tracking
Individual prices
Selected shop
Session
Comfort functions
These cookies are used to make the shopping experience even more appealing, for example for the recognition of the visitor.
Note
Show the facebook fanpage in the right blod sidebar
Statistics & Tracking
Affiliate program
Conversion and usertracking via Google Tag Manager
Track device being used
| Item number | Size | Datasheet | Manual | SDS | Delivery time | Quantity | Price |
|---|---|---|---|---|---|---|---|
| NSJ-FY13316 | 100 µg | - | - |
3 - 10 business days* |
790.00€
|
If you have any questions, please use our Contact Form.
You can also order by e-mail: info@biomol.com
Larger quantity required? Request bulk
You can also order by e-mail: info@biomol.com
Larger quantity required? Request bulk
Adding 0.2 ml of distilled water will yield a concentration of 500 ug/ml. TIMM50 antibody... more
Product information "Anti-TIMM50 / Translocase of inner mitochondrial membrane 50"
Adding 0.2 ml of distilled water will yield a concentration of 500 ug/ml. TIMM50 antibody recognizes Translocase of inner mitochondrial membrane 50, a mitochondrial inner membrane protein encoded by the TIMM50 gene on chromosome 19q13.2. TIMM50 is a key component of the TIM23 complex, which mediates the import of preproteins from the cytosol into the mitochondrial matrix or inner membrane. This protein functions as the receptor subunit of the TIM23 complex, recognizing presequence-containing mitochondrial proteins and guiding them through the translocase channel. TIMM50 antibody identifies a mitochondrial protein critical for energy metabolism, apoptosis regulation, and mitochondrial biogenesis.Structurally, TIMM50 consists of an N-terminal mitochondrial targeting sequence, a single transmembrane domain anchoring it to the inner membrane, and a large C-terminal domain extending into the mitochondrial matrix. The matrix-exposed domain interacts directly with imported polypeptides and regulatory subunits such as TIM23 and TIM17. TIMM50 also contains conserved residues required for phosphatase-like activity and structural stabilization of the import pore. Its expression is ubiquitous but highest in energy-demanding tissues such as heart, skeletal muscle, and brain.TIMM50 functions within the mitochondrial protein import pathway, ensuring proper localization of enzymes required for oxidative phosphorylation (OXPHOS). Disruption of TIMM50 function leads to accumulation of preproteins in the cytosol and mitochondrial dysfunction. The protein participates in maintaining mitochondrial membrane potential and overall organelle integrity. In addition to import regulation, TIMM50 has been linked to apoptosis modulation through interactions with BCL-2 family proteins.Clinically, biallelic pathogenic variants in TIMM50 cause combined oxidative phosphorylation deficiency 35 (COXPD35), characterized by developmental delay, hypotonia, seizures, and elevated lactate levels. Loss of TIMM50 function impairs respiratory chain complex assembly and ATP production, reflecting its essential role in mitochondrial bioenergetics. Some studies also associate TIMM50 mutations with epilepsy and progressive encephalopathy, highlighting its neurodevelopmental relevance.Pathway involvement of TIMM50 includes mitochondrial protein import machinery and the oxidative phosphorylation pathway, where it contributes indirectly to ATP generation and ROS regulation. Structural and functional conservation of the TIM23 complex across eukaryotes underscores the evolutionary importance of TIMM50 in mitochondrial function. The protein family classification places TIMM50 within the TIM/TOM translocase family responsible for mitochondrial protein trafficking.Immunohistochemical staining using TIMM50 antibody reveals strong mitochondrial localization in cardiac and neuronal tissues. The TIMM50 antibody from NSJ Bioreagents provides a robust tool for research into mitochondrial import mechanisms, bioenergetics, and inherited mitochondrial disease.
| Keywords: | Anti-TIMM50, Anti-Mitochondrial import inner membrane translocase subunit TIM50, TIMM50 Antibody / Translocase of inner mitochondrial membrane 50 |
| Supplier: | NSJ Bioreagents |
| Supplier-Nr: | FY13316 |
Properties
| Application: | WB, IHC, ICC/IF, FC, ELISA |
| Antibody Type: | Polyclonal |
| Conjugate: | No |
| Host: | Rabbit |
| Species reactivity: | human, mouse, rat |
| Immunogen: | E.coli-derived human TIMM50 recombinant protein (Position: F8-Q324) |
| Format: | Purified |
Database Information
| KEGG ID : | K17496 | Matching products |
| UniProt ID : | Q3ZCQ8 | Matching products |
| Gene ID : | GeneID 92609 | Matching products |
Handling & Safety
| Storage: | +4°C |
| Shipping: | +4°C (International: +4°C) |
Caution
Our products are for laboratory research use only: Not for administration to humans!
Our products are for laboratory research use only: Not for administration to humans!
Information about the product reference will follow.
more
You will get a certificate here
Viewed